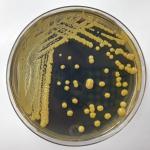

JB: A new report in USA Today is certainly looking for readers. The title clearly reflects this:
“Not 'if' but 'when': Antibiotic resistance poses an existential threat for modern medicine”
Dr. David Shlaes
This is both the end and the beginning of an era. I started writing a book, Antibiotics – The Perfect Storm, in 2009 (it was published in 2010). I began writing the blog at the same time.
I want to discuss the idea of superiority trials for antibiotics and some of the issues that many experienced researchers fail to consider when thinking about this topic. I am grateful to George Drusano for his input here.
Recent discussions on the economics of innovation in rapid diagnostic testing for bacterial infections in the hospital setting have inspired me to once again take pen (keyboard) in hand.
I never dreamed this would be possible. Of course, so many things are possible today that I thought were impossible that I’m almost embarrassed to admit it (but I have no pride).
Over the past few months I've been arguing that remdesivir, the only approved drug for SARS-2 infection, was never going to make a meaningful impact on COVID because it is an IV-only drug, meaning that it will only be administered to ver
I thought that this would be a good time to review the various vaccines and therapies being studied to combat the coronavirus pandemic.
# Reprinted with permission from Dr. Shlaes' blog. The original post can be found here.
This is not the MRSA pandemic, ladies and gentlemen. Let's take a look at the MRSA pandemic. In US hospitals, even today (latest CDC data is from 2014), 46% of S.